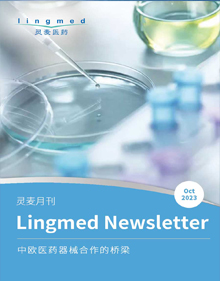

Linkedbio灵佰是灵麦医药新推出的项目对接服务,灵麦团队在全球范围内精选优质新药和器械项目,帮助国内医药和器械企业与国外创新研发公司建立商业联系。
为客户提供目标治疗领域的项目初步市场分析,与项目研发公司安排对接会议,线上翻译,提供项目非保密资料,并提供首次洽谈会议后的项目跟进等,帮助国内公司引进创新产品
灵麦分析团队通过对文献搜索分析(包括公司年报和其他新闻评论等)及一线访谈帮助我们的客户完成市场项目分析工作, 包括产品在中国的市场销量预估,交易的估值和竞争情报分析报告等
![]() |
灵麦创新合作项目推荐 第425期欧洲创新皮肤肿瘤项目寻求中国合作伙伴 (LMP2804)
|
![]() |
灵麦创新合作项目推荐 第423期美国创新抗感染项目——治疗急性呼吸道病毒感染 寻求中国合作伙伴 (LMP2802)
|
![]() |
灵麦月刊 2025年12月在本期的月刊中,灵麦医药和您分享以下信息
|
![]() |
灵麦创新合作项目推荐 第420期美国创新中枢神经疾病项目——治疗耐药性癫痫寻求中国合作伙伴 (LMP2800)
|
![]() |
灵麦创新合作项目推荐 第417期美国创新治疗阿尔茨海默病项目 寻求中国合作伙伴 (LMP2791)
|
![]() |
灵麦创新合作项目推荐 第416期欧洲创新呼吸疾病项目——治疗支气管哮喘 寻求中国合作伙伴 (LMP2796)
|
![]() |
灵麦创新合作项目推荐 第415期欧洲创新自免/炎症项目——治疗类风湿性关节炎 寻求中国合作伙伴 (LMP1278)
|
![]() |
灵麦创新合作项目推荐 第414期欧洲创新治疗类风湿关节炎 寻求中国合作伙伴LMP2795
|
![]() |
灵麦月刊 2025年10月在本期的月刊中,灵麦医药和您分享以下信息
|
![]() |
灵麦月刊 2025年9月在本期的月刊中,灵麦医药和您分享以下信息
|
![]() |
灵麦创新合作项目推荐 第409期欧洲肥胖&抗衰老项目寻求中国合作LMP1155
|
![]() |
灵麦创新合作项目推荐 第408期欧洲创新机制帕金森病项目寻求中国合作LMP2788
|
![]() |
灵麦月刊 2025年8月在本期的月刊中,灵麦医药和您分享以下信息
|
![]() |
灵麦创新合作项目推荐 第406期欧洲创新靶点治疗肠道炎性疾病项目寻求中国合作LMP2785
|
![]() |
灵麦月刊 2025年7月在本期的月刊中,灵麦医药和您分享以下信息
|
![]() |
灵麦创新合作项目推荐 第404期欧美III期治疗重度抑郁症创新项目寻求中国合作 LMP2787
|
![]() |
灵麦月刊 2025年6月在本期的月刊中,灵麦医药和您分享以下信息
|
![]() |
灵麦创新合作项目推荐 第401期欧洲临床一期新药治疗痤疮项目寻求中国合作 - LMP1999
|
![]() |
灵麦月刊 2025年5月在本期的月刊中,灵麦医药和您分享以下信息
|
![]() |
灵麦创新合作项目推荐 第399期德国II/III期创新血清眼药水治疗干眼症 -LMP2783
|
![]() |
灵麦月刊 2025年4月在本期的月刊中,灵麦医药和您分享以下信息
|
![]() |
灵麦月刊 2025年2月在本期的月刊中,灵麦医药和您分享以下信息
|
![]() |
灵麦月刊 2025年1月在本期的月刊中,灵麦医药和您分享以下信息
|
![]() |
灵麦月刊 2024年12月在本期的月刊中,灵麦医药和您分享以下信息
|
![]() |
灵麦创新合作项目推荐 第389期新机制雄激素性秃发项目寻求中国合作- LMP2606
|
![]() |
灵麦创新合作项目推荐 第388期海外Me better 肠道炎症项目寻求中国合作- LMP2703
|
![]() |
灵麦月刊 2024年11月在本期的月刊中,灵麦医药和您分享以下信息
|
![]() |
灵麦月刊 2024年10月在本期的月刊中,灵麦医药和您分享以下信息
|
![]() |
灵麦创新合作项目推荐 第383期美国恶性胸膜间皮瘤治疗新突破LMP2711
|
![]() |
灵麦创新合作项目推荐 第381期欧洲创新口服癫痫药物寻求中国合作 - LMP2719
|
![]() |
灵麦月刊 2024年9月在本期的月刊中,灵麦医药和您分享以下信息
|
![]() |
灵麦创新合作项目推荐 第380期欧洲高潜力FLT3抑制剂药物项目寻求全球合作 LMP1249
|
![]() |
灵麦创新合作项目推荐 第378期首创新药雄激素性脱发项目寻求中国合作 LMP1828
|
![]() |
灵麦月刊 2024年8月在本期的月刊中,灵麦医药和您分享以下信息
|
![]() |
灵麦创新合作项目推荐 第377期海外过敏性疾病项目寻求全球合作 LMP1957
|
![]() |
灵麦创新合作项目推荐 第376期实体肿瘤ADC项目寻求中国合作 LMP1983
|
![]() |
灵麦月刊 2024年7月在本期的月刊中,灵麦医药和您分享以下信息
|
![]() |
灵麦创新合作项目推荐 第373期欧洲创新抗生素耐药项目寻求全球合作 LMP2661
|
![]() |
灵麦创新合作项目推荐 第372期欧洲创新银屑病治疗新突破项目寻求全球合作LMP2663
|
![]() |
灵麦月刊 2024年6月在本期的月刊中,灵麦医药和您分享以下信息
|
![]() |
灵麦创新合作项目推荐 第370期美国HER2+胃癌/乳腺癌双抗项目寻求中国合作 LMP2658
|
![]() |
灵麦创新合作项目推荐 第369期阿尔兹海默症最新突破寻求中国合作 LMP1888
|
![]() |
灵麦创新合作项目推荐 第367期创新关节内注射剂治疗关节疼痛项目寻求中国合作-LMP2660
|
![]() |
灵麦创新合作项目推荐 第366期慢性炎症肠病IBD的新靶点的早期创新突破寻求中国合作
|
![]() |
灵麦月刊 2024年4月在本期的月刊中,灵麦医药和您分享以下信息
|
![]() |
灵麦创新合作项目推荐 第364期北美自身免疫性罕见病项目寻求中国合作- LMP2001
|
![]() |
灵麦创新合作项目推荐 第362期欧洲类风湿性关节炎项目寻求全球合作- LMP1898
|
![]() |
灵麦月刊 2024年3月在本期的月刊中,灵麦医药和您分享以下信息
|
![]() |
灵麦创新合作项目推荐 第361期外周 T 细胞淋巴瘤项目寻求全球合作- LMP1997
|
![]() |
灵麦创新合作项目推荐 第359期欧洲一期口服治疗实体瘤创新项目寻求中国研发合作 LPM1996
|
![]() |
灵麦月刊 2024年2月在本期的月刊中,灵麦医药和您分享以下信息
|
![]() |
灵麦创新合作项目推荐 第358期欧洲呼吸道疾病项目寻求全球合作 LMP2003
|
![]() |
灵麦创新合作项目推荐 第356期澳洲肿瘤创新靶点CAR-T项目寻求全球合作 LMP2669
|
![]() |
灵麦月刊 2024年1月在本期的月刊中,灵麦医药和您分享以下信息
|
![]() |
灵麦创新合作项目推荐 第355期骨关节炎治疗药物项目寻求全球合作 LMP1991
|
![]() |
灵麦创新合作项目推荐 第354期双机制急性中风&中风后抑郁项目寻求全球合作 LMP1988
|
![]() |
灵麦月刊 2023年12月在本期的月刊中,灵麦医药和您分享以下信息
|
![]() |
灵麦创新合作项目推荐 第352期肿瘤创新靶点精准医疗核药项目寻求全球合作 LMP1938
|
![]() |
灵麦创新合作项目推荐 第351期首创瘢痕治疗项目寻求全球合作LMP1835
|
![]() |
灵麦月刊 2023年11月在本期的月刊中,灵麦医药和您分享以下信息
|
![]() |
灵麦创新合作项目推荐 第349期美国创新 - 缓释口服治疗2型糖尿病项目寻求全球合作 - LMP1992 LMP1993
|
![]() |
灵麦创新合作项目推荐 第348期欧洲吸入式偏头痛项目寻求中国合作- LMP1987
|
![]() |
灵麦月刊 2023年10月在本期的月刊中,灵麦医药和您分享以下信息
|
![]() |
灵麦创新合作项目推荐 第346期创新突破 - 口服治疗老年黄斑病变眼病- LMP1982
|
![]() |
灵麦月刊 2023年9月在本期的月刊中,灵麦医药和您分享以下信息
|
![]() |
灵麦创新合作项目推荐 第344期长效肺动脉高压新药- 寻求全球合作-LMP1854
|
![]() |
灵麦创新合作项目推荐 第343期欧洲长效预装前列腺癌项目寻求全球合作-LMP1855
|
请确认您的信息